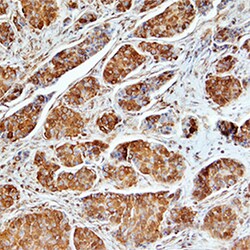
Human Osteopontin/OPN Antibody, R D Systems 25&mu;g; Unlabeled:Antikroppar

missing translation for 'onlineSavingsMsg'
Läs mer
Läs mer
Human Osteopontin/OPN Antibody, R&D Systems™


Mouse Monoclonal Antibody has been used in 4 publications
Brand: R&D Systems MAB1433-SP
Denna artikel kan inte returneras.
Se returpolicy
Beskrivning
Osteopontin/OPN Monoclonal specifically detects Osteopontin/OPN in Human samples. It is validated for Immunohistochemistry.
Specifikationer
| Osteopontin/OPN | |
| Monoclonal | |
| LYOPH | |
| Immunohistochemistry 8-25 ug/mL | |
| NP_000573.1 | |
| SPP1 | |
| Mouse myeloma cell line NS0-derived recombinant human Osteopontin Ile17-Asn300 Accession # NP_000573.1 | |
| 25 μg | |
| Primary | |
| Detects human Osteopontin in direct ELISAs. | |
| Human | |
| Purified |
| Immunohistochemistry | |
| 190312 | |
| Unconjugated | |
| Lyophilized from a 0.2 μm filtered solution in PBS with Trehalose. *Small pack size (SP) is supplied as a 0.2 μm filtered solution in PBS. with No Preservative | |
| BNSP, Bone sialoprotein 1, Eta-1, MGC110940, Nephropontin, OPN, osteopontin, secreted phosphoprotein 1bone sialoprotein I, early T-lymphocyteactivation 1), secreted phosphoprotein-1 (osteopontin, bone sialoprotein), Spp1, SPP-1, SPP1/CALPHA1 fusion, Urinary stone protein, uropontin | |
| Mouse | |
| Protein A or G purified from hybridoma culture supernatant | |
| RUO | |
| 6696 | |
| Reconstitute at 0.5 mg/mL in sterile PBS. | |
| Use a manual defrost freezer and avoid repeated freeze-thaw cycles. 12 months from date of receipt, -20 to -70 degreesC as supplied. 1 month, 2 to 8 degreesC under sterile conditions after reconstitution. 6 months, -20 to -70 degreesC under sterile conditions after reconstitution. | |
| IgG2b |
Korrigering av produktinnehåll
Din input är viktig för oss. Fyll i det här formuläret för att ge feedback relaterad till innehållet på denna produkt.
Produkttitel
For Research Use Only
Hittar du en möjlighet till förbättring?Dela en innehållskorrigering